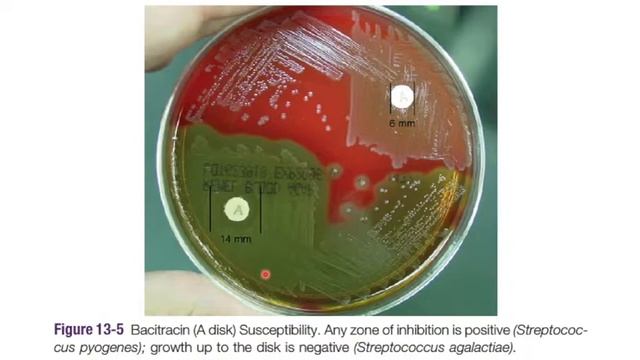
Cocos gram positivos: Algoritmo de identificación || Staphylococcus, Streptococcus, Enterococcus || смотреть онлайн

Автор / Канал: Charming Communicators Страница 8

1926444

"Просто о сложном"

Гербицид Глифовит Экстра

38vo. Congreso Nacional de Ortopedia y Traumatologia 2017

Incredible Body Transformation - Kimmerleplan

S1E5: Myth Busting Bariatric Surgery

Story of a Living Donor - Daughter Donated Liver to her Father - Liver Transplant Surgery.

How Farmers Earn Million from Processing Python Skin in Processing Factory

FM (FORCES ON VERTICAL & INCLINED BODY , BUOYANCY) AE PSC QUESTIONS -7

Сирия. У боевика началась истерика - его штаб разнесли...

The Derma co 10%Niacinamide Serum for Acne marks|My Honest Review||1 Month experience@Aathiestipz

Капуста Гальватрон F1. ООО ЭкоФреш. 27 сентября 2023.#cabbage #агроном #капуста #овощи #семенаовоще

The Present and Future of HiFi Whole-Genome Sequencing for Rare Disease

ABÓBORA KABOCHA OU CABOTIÁ FERMENTADA E PROBIÓTICA

GENETIKA KUANTITATIF 1 | PENGANTAR | BELAJAR GENETIKA

Desahogo Norteno - El Compa 1

Elderwind - live (Неглубокая могила 2022)

An die Musik_F. Schubert Práctica Coral UIS_Festival Coral Santander 2021 Dir: Luz Helena Peñaranda

Si, mi chiamano Mimi - Dunja Simic

Ramon Escale, Lluis Ribalta, Ignasi Zamora - ERZ Cafè - Moliendo café (Reprise)
Cocos gram positivos: Algoritmo de identificación || Staphylococcus, Streptococcus, Enterococcus ||

Титаник номер 69! - Karaoke Party част 1

Підозрюваному у зґвалтуванні школярки обрано міру запобіжного заходу у вигляді тримання під вартою

Москва, декабрь 2021г. Ярмарка на Красной площади.
За каждым успешным каналом стоит личность, идея и сотни часов кропотливого труда. Если вы здесь, значит, автор «Charming Communicators» уже сумел зацепить ваше внимание своим уникальным стилем или подачей. А мы на RUVIDEO позаботились о том, чтобы вы могли изучить весь архив его работ в максимально комфортных условиях — без лишней суеты и преград.
Почему за работами канала «Charming Communicators» так интересно наблюдать? Всё просто: это честный контент, который находит отклик в сердцах зрителей. На нашем ресурсе вы можете смотреть онлайн все видео любимого автора бесплатно и в хорошем качестве. Нам важно, чтобы вы видели каждую деталь и слышали каждый нюанс, поэтому мы используем только стабильные плееры из открытых источников Rutube.
Следите за новинками канала, пересматривайте старые шедевры и открывайте для себя новые грани творчества «Charming Communicators». Мы постоянно обновляем ленту, чтобы у вас под рукой всегда были самые свежие выпуски. Никаких сложных регистраций — только вы и творчество, которое вдохновляет. Приятного вам путешествия по миру авторского контента на RUVIDEO!
Видео взято из открытых источников Rutube. Если вы правообладатель, обратитесь к первоисточнику.